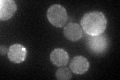
YBR052C
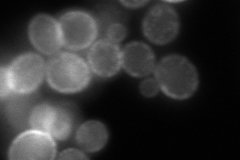
YBR052C

View description
Protein of unknown function; member of a flavodoxin-like fold protein family that includes Pst2p and Ycp4p; green fluorescent protein (GFP)-fusion protein localizes to the cytoplasm in a punctate pattern
Localization:
Intensity:
Fold change:
Significance:
-
C’ GFP library in SD
punctate73.51 -
N' NOP1pr-GFP in SD

cell periphery,punctate124.669 -
N' TEF2pr-mCherry in SD
cell periphery,punctate84.5941 -
N' NATIVEpr-GFP in SD

cell periphery,punctate43.1946 -
N' TEF2pr-VC and Cyto-VN in SD

cell periphery36.9194 -
C’ GFP library in SD+DTT

punctate98.651.34No -
C’ GFP library in SD+H2O2

punctate69.460.94No -
C’ GFP library in Starvation Media

punctate131.351.78Yes -
C’ GFP library on the background of Pup2-DaMP

punctate -
C’ GFP library on the background of CCT mutant

punctate84.74421.15265No
